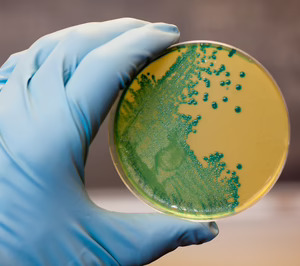
El CSIC patenta un cóctel enzimático sostenible para combatir la listeria

Entre los enemigos que ponen en riesgo nuestros alimentos, Listeria monocytogenes destaca como uno de los patógenos más peligrosos, causando decenas de muertes cada año, especialmente en personas inmunodeprimidas, mujeres embarazadas, adultos mayores y niños. Su control representa un desafío para la industria alimentaria. Actualmente, las empresas del sector utilizan desinfectantes químicos como compuestos clorados, sales de amonio o alcoholes, que son muy efectivos pero presentan desventajas: pueden conllevar un riesgo para la salud humana y generan residuos tóxicos.
Ahora, investigadores del Consejo Superior de Investigaciones Científicas (CSIC) en el Instituto de Agroquímica y Tecnología de Alimentos (IATA) y el Instituto de Biología Molecular y Celular de Plantas (IBMCP, CSIC-UPV), han patentado han patentado un nuevo método basado en una combinación de enzimas para combatir a esta bacteria. Combinando dos herramientas biológicas han logrado eliminar hasta el 99,99% de las células de listeria en ensayos. Además de eficaz, este nuevo método es inocuo y no genera residuos peligrosos, teniendo así un gran potencial para su aplicación directa en alimentos.
"Separadas, estas enzimas tienen una eficacia limitada, pero juntas lograron un efecto sinérgico excelente contra Listeria monocytogenes, debido a que presentan distintos modos de acción", argumenta Julia Marín, investigadora del IATA y profesora de la Universitat de València que participa en el estudio. La primera degrada la pared celular de las bacterias, mientras que la segunda genera peróxido de hidrógeno (agua oxigenada), agente oxidativo que resulta letal.
Esta combinación ha permitido además reducir las concentraciones de glucosa oxidasa y endolisina para lograr un efecto antimicrobiano, minimizando posibles efectos adversos sobre las características y propiedades organolépticas de los alimentos. "La estrategia empleada es muy efectiva para la limpieza de superficies en entornos alimentarios, y presenta un gran potencial para su aplicación directa en alimentos en el futuro", añade Julio Polaina, integrante del equipo de investigación del IATA-CSIC.
Además, "la probabilidad de que las bacterias desarrollen resistencia a ambas enzimas de forma simultánea es baja, dada la naturaleza combinada y específica del tratamiento", concluye. "Este enfoque no solo es eficaz, sino también respetuoso con el medio ambiente. A diferencia de los desinfectantes químicos tradicionales, estas enzimas no son tóxicas, ni tampoco generan residuos peligrosos", amplía José Antonio Darós, investigador del CSIC en el IBMCP que participa en la investigación.